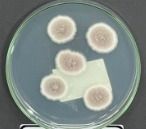

[ VitalForce Line ]
VitalForce stands out for its innovative infrastructure and continuous investment in Research and Development. With high-performance products, the company offers three distinct categories, ready to serve customers, distributors and resellers. The team is prepared to guarantee the best experience and profitability for its partners.
Biological Control based on the fungus Isaria
VitalForce presents biological pest control products based on the Isaria fungus. Imagine that this control not only protects your crops, but also respects the delicate balance of nature. With this control, you are not only adopting an effective solution; you are joining a new era of sustainable agricultural practices. This technology in VitalForce products demonstrates the way we approach pest control to promote a healthier and more productive environment. Come and discover how VitalForce's excellence can transform your crop into a true example of harmony between productivity and sustainability!
Benefits of Using VitalForce Products
[ Increased Productivity: ]
Our products are formulated to maximize the efficiency and productivity of your crop, resulting in more abundant harvests.
[ Environmental Sustainability ]
VitalForce solutions are developed with a focus on preserving the environment, ensuring more sustainable agricultural practices.
[ Quality Guaranteed ]
With VitalForce, you can be sure that you are using high-quality products, tested and approved to deliver the best results.
LAUNCH
IN NEMATODE MANAGEMENT, what was good came back even better.
Safety and high synergy of bacteria (bacillus subtilis strain CCT0480) and fungus (trichoderna harzianum strain CCT2160) strains
Exclusive high-performance strains that prevent the development of resistance.
Greater rooting and initial start-up that favors greater absorption of water and nutrients resulting in greater productivity.
Liquid formulation that facilitates handling.
Best cost-benefit ratio on the market.
MAPA Registration 31923